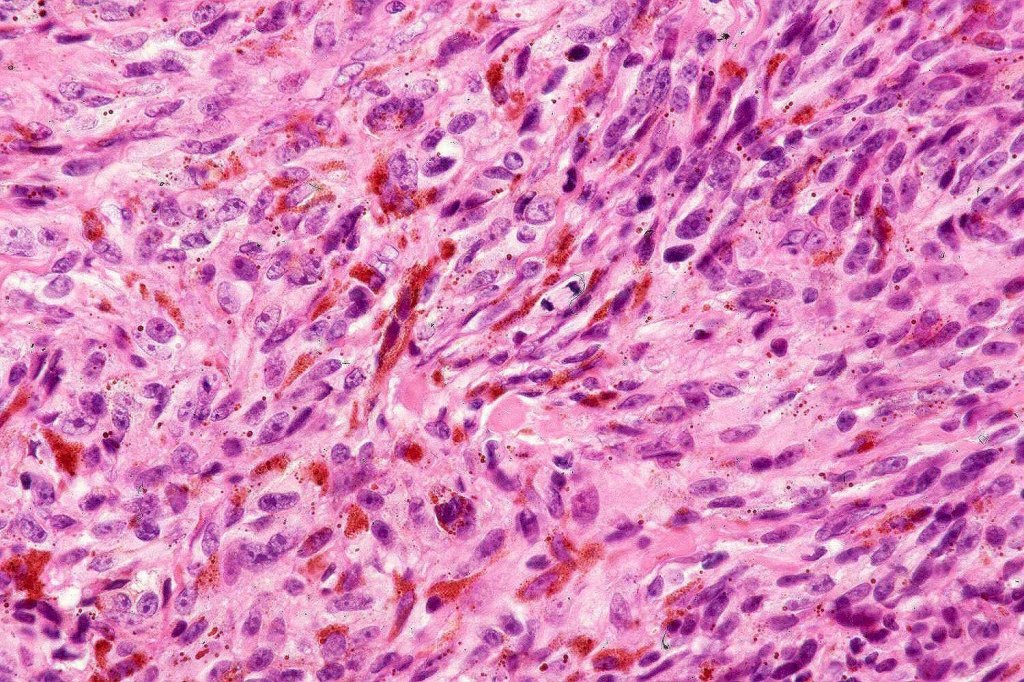
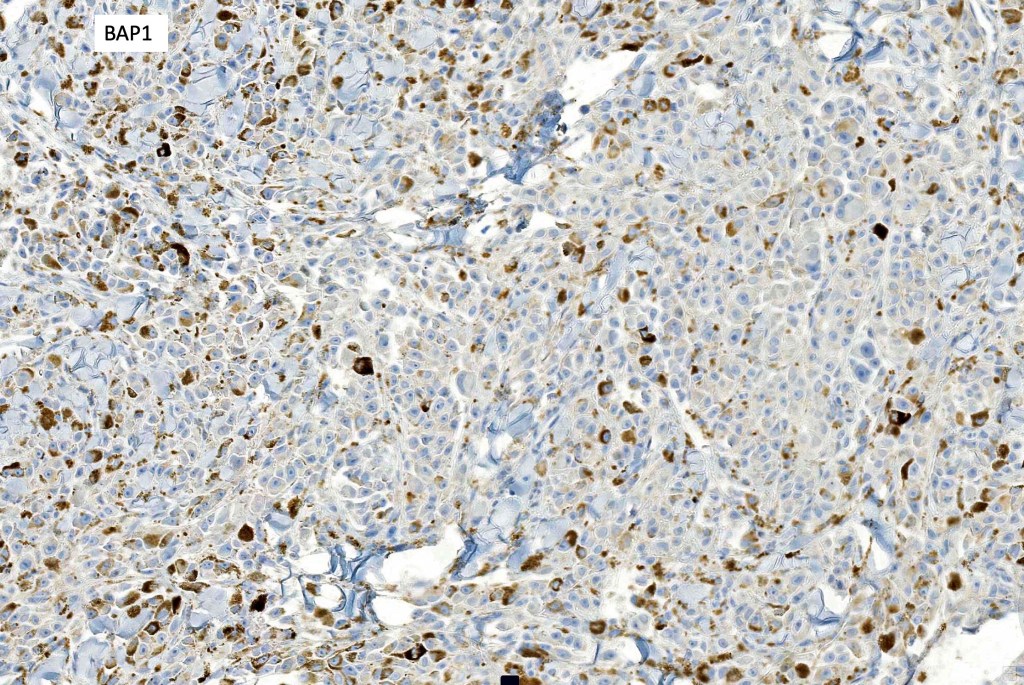
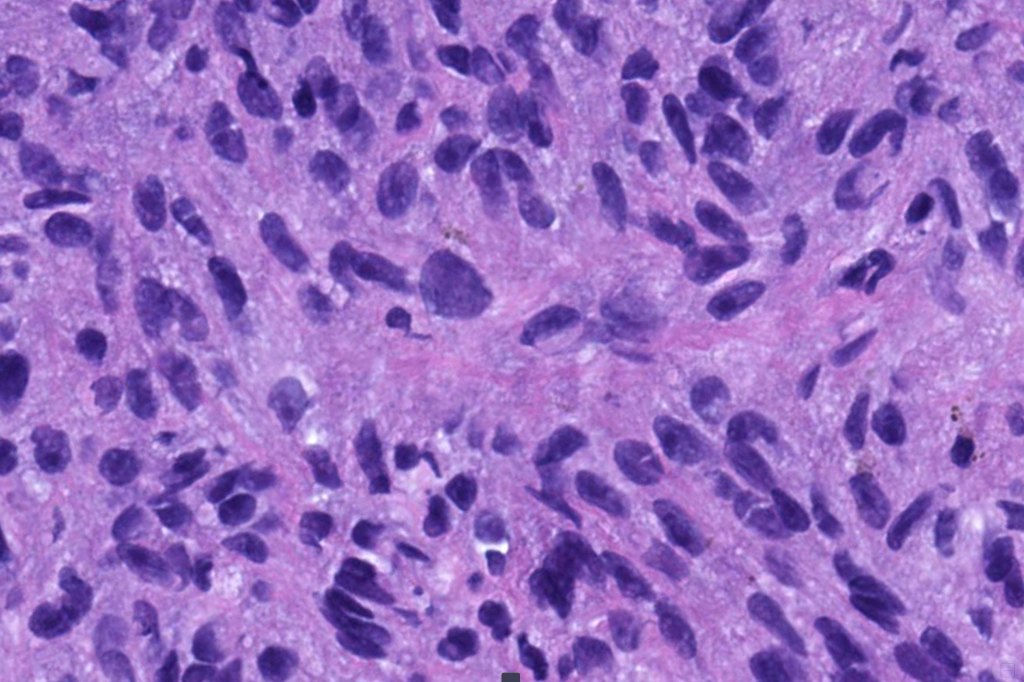

Two subtypes
- Melanoma arising in a pre-existent blue nevus (common or more often cellular) or denritic melanocytosis including nevus of Ota, Ita & pilar neurocristic hamtoma
- Melanoma in which blue nevus-like features (dendritic cells & melanophages) are seen within a spindled or epithelioid melanoma
Clinical features
•Usually slowly growing tumors
•Predilection for the scalp
•M>F
•No age predilection & exceptionally, lesions can develop in children
•High grade tumor probably related to delay in diagnosis & hence marked tumor thickness
•Metastases develop in around 50% of cases to lymph nodes, lung & liver
Histological features
•Develops within a precursor lesion as one or more nodules of epithelioid or spindled cell melanoma
•Or melanoma showing admixed blue nevus-like features (dendritic cells and melanophages) in the absence of a precursor lesion
•The latter may show a dumbbell appearance at low power or scanning magnification
•Nuclear pleomorphism with prominent nucleoli, mitotic activity & abnormal mitoses
•Necrosis sometimes present
•Occasionally perineural infiltration or vascular invasion seen
•Mutations in DNAQ or GNA11, Mutations in BAP1, SF3B1 & E1F1AX
Melanoma arising in a pliar neurocristic hamartoma

Leave a comment